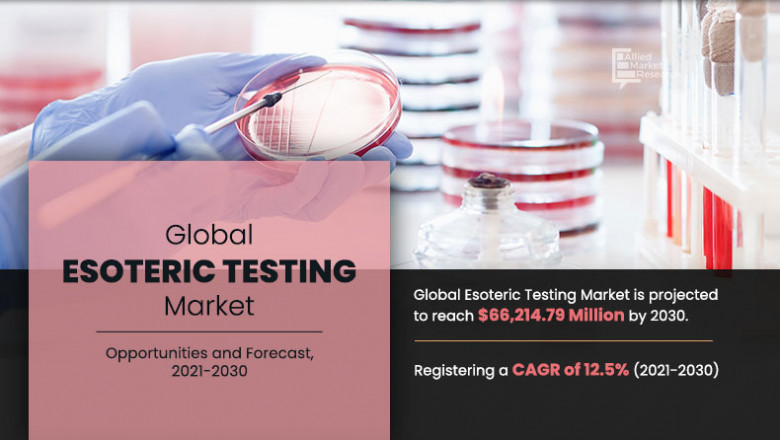

views
The report provides an in-depth analysis of the top investment pockets, top winning strategies, drivers & opportunities, market size & estimations, competitive scenario, and wavering market trends.
For Right Perspective and Competitive Insights, Get Sample Report at: https://www.alliedmarketresearch.com/request-sample/12387
Increase in prevalence of chronic, infectious, and genetic diseases, rise in demand for ELISA and RT-PCR test, surge in number of medical laboratories, and growth in awareness among individuals regarding early diagnosis detection & personalized medicines fuel the global esoteric testing market. On the other hand, high cost for esoteric testing and lack of skilled professionals & laboratory technicians impede the growth to some extent. However, upsurge in technological advancement in esoteric testing is expected to create lucrative opportunities in the industry.
COVID-19 scenario-
The outbreak of the pandemic has given way to rise in demand for real-time polymerase chain reaction (RT-PCR) test to detect COVID-19, thereby impacting the global esoteric testing market positively.
This trend is most likely to continue till the virus is completely gone.
The global esoteric testing market is analyzed across type, technology, end user, and region. Based on type, the infectious disease testing segment held the major share in 2020, garnering more than one-fifth of the total market. The genetic testing segment, however, would cite the fastest CAGR of 14.40% during the forecast period.
Do You Have Any Query Or Specific Requirement? Ask to Our Industry Expert: https://www.alliedmarketresearch.com/purchase-enquiry/12387
By technology, the chemilumescence immunoassay segment accounted for around one-fourth of the total market revenue in 2020, and is anticipated to retain its dominance by 2030. The DNA sequencing segment, on the other hand, would grow at the fastest CAGR of 15.40% from 2021 to 2030.
Based on region, the market across North America contributed to the major share in 2020, holding nearly three-fifths of the global esoteric testing market. The Asia-Pacific region would grow at the fastest CAGR by 13.40% from 2021 to 2030. The other provinces studied in the report include Europe and LAMEA.
The key market players analyzed in the global esoteric testing market report include Baylor Esoteric and Molecular Laboratory, Sonic Healthcare Limited, Healius Limited, Foundation Medicine, Laboratory Corporation, Mayo Foundation for Medical Education and Research, ARUP Laboratories, OPKO Health, Stanford Clinical Pathology, and Quest Diagnostics. These market players have incorporated several strategies including partnership, expansion, collaboration, joint ventures, and others to brace their stand in the industry.












